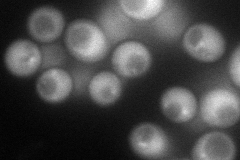
YKL041W
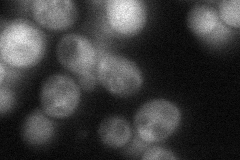
YKL041W
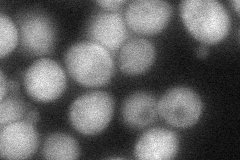
YKL041W

View description
One of four subunits of the endosomal sorting complex required for transport III (ESCRT-III); forms an ESCRT-III subcomplex with Did4p; involved in the sorting of transmembrane proteins into the multivesicular body (MVB) pathway
Localization:
Intensity:
Fold change:
Significance:
-
C’ GFP library in SD

punctate35.95 -
N' NOP1pr-GFP in SD
cytosol,punctate92.3453 -
N' TEF2pr-mCherry in SD

cytosol224.584 -
N' NATIVEpr-GFP in SD
cytosol,punctate49.3538 -
N' TEF2pr-VC and Cyto-VN in SD
cytosol51.368 -
C’ GFP library in SD+DTT

punctate39.461.09No -
C’ GFP library in SD+H2O2

punctate27.590.76No -
C’ GFP library in Starvation Media

punctate31.880.88No -
C’ GFP library on the background of Pup2-DaMP

punctate -
C’ GFP library on the background of CCT mutant

punctate28.9290.80454No
